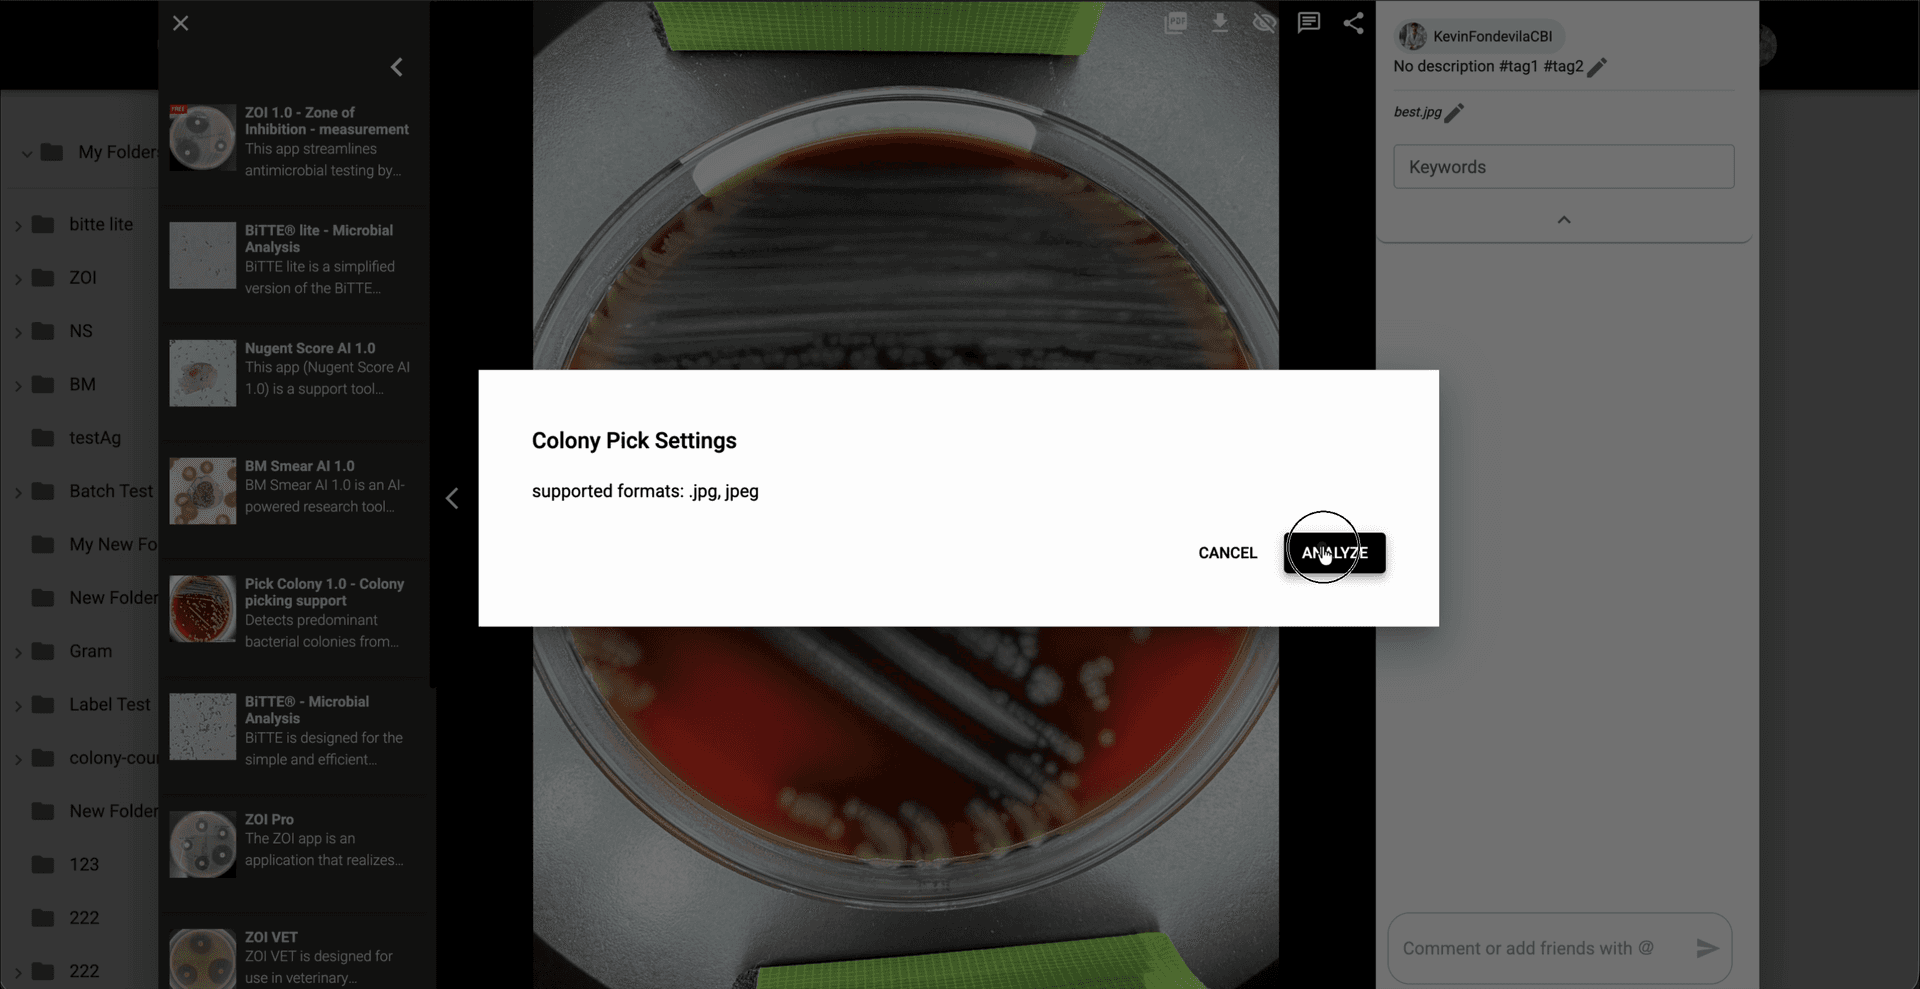
Step 3: En Colony Pick Settings, revisa el formato soportado y haz clic en 'Analyze' para iniciar el análisis de selección de colonias por defecto.
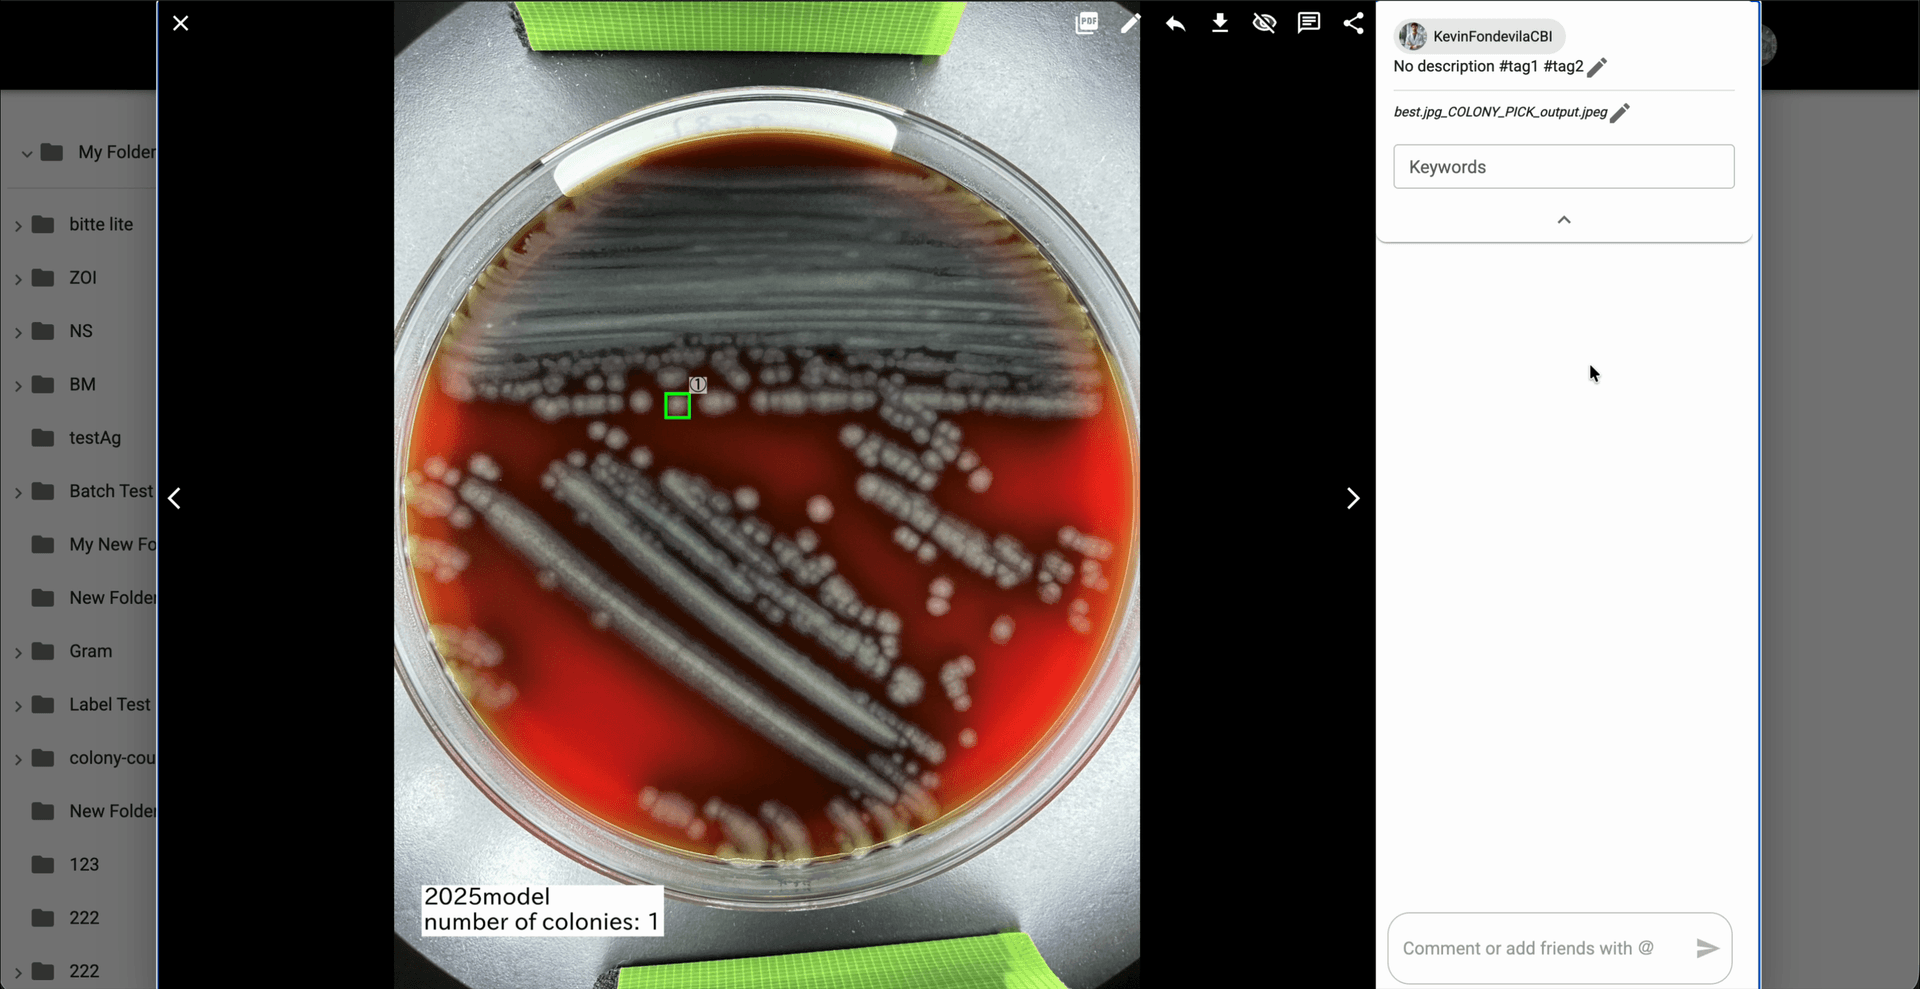
Step 5: Revisa la imagen generada `_COLONY_PICK_output` y confirma la colonia resaltada junto con el resumen `number of colonies` que aparece en el resultado.
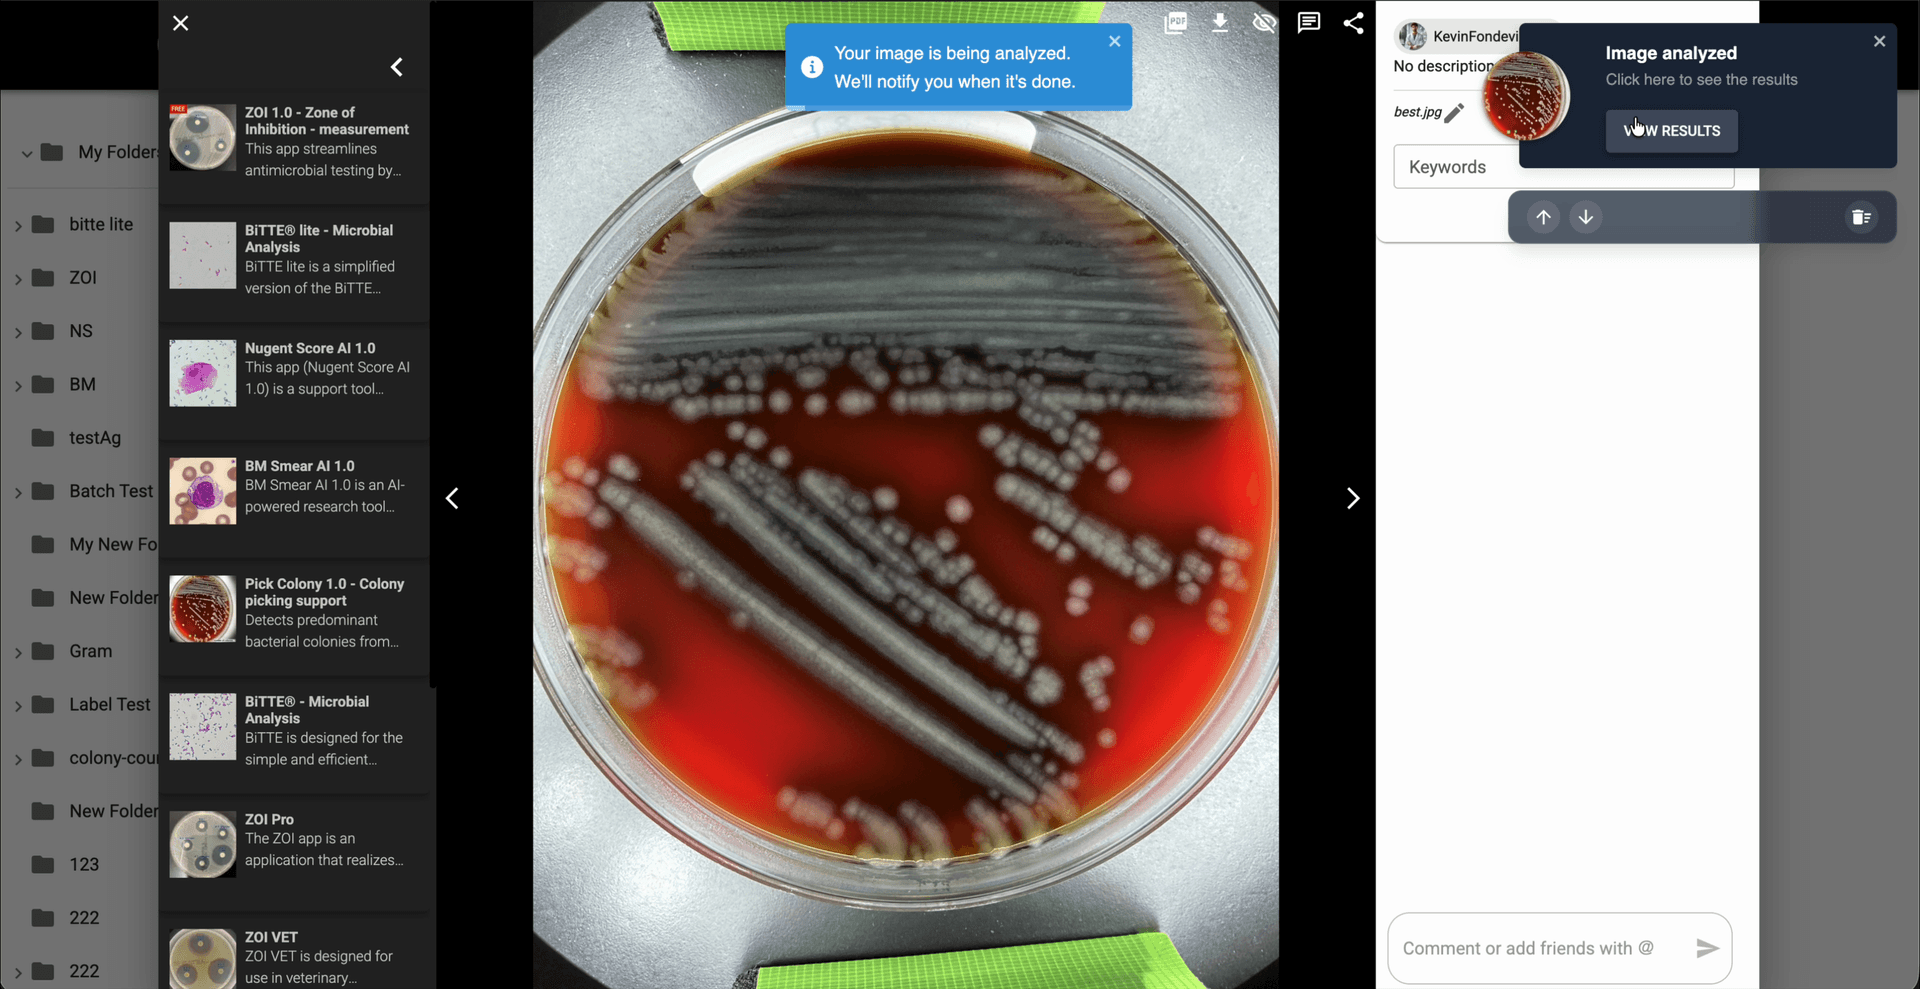
Step 4: Espera a que termine el análisis y luego usa 'View Results' en la notificación para abrir la imagen de resultado generada.
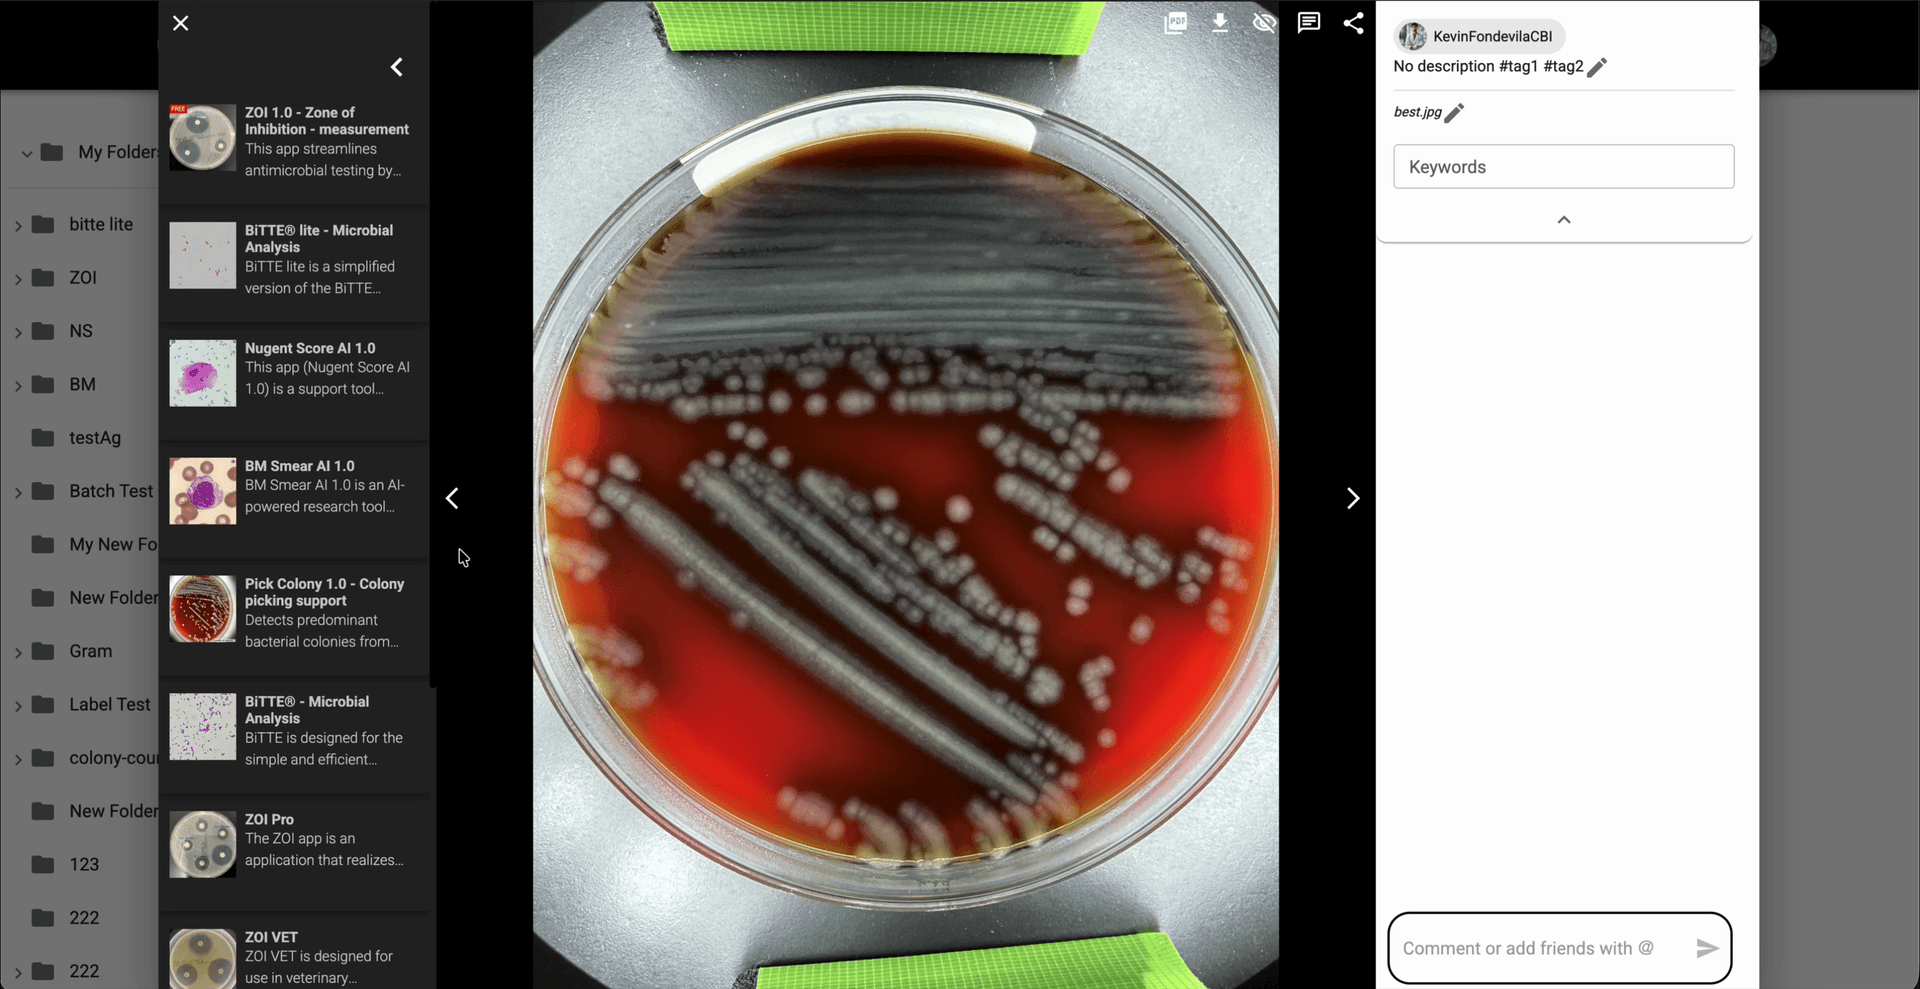
Step 2: En el modal de imagen, haz clic en la tarjeta de Pick Colony dentro de la lista de aplicaciones para abrir su flujo de análisis.

Como usar Pick Colony 1.0 - Colony Picking support
ES
Usa Pick Colony para detectar la colonia predominante en una imagen de placa y generar una imagen de salida que resalte la colonia seleccionada y el recuento detectado de colonias.
Desde la galeria, abre en el modal de imagen una imagen de placa con colonias bacterianas visibles.
En el modal de imagen, haz clic en la tarjeta de Pick Colony dentro de la lista de aplicaciones para abrir su flujo de análisis.

En Colony Pick Settings, revisa el formato soportado y haz clic en 'Analyze' para iniciar el análisis de selección de colonias por defecto.

Espera a que termine el análisis y luego usa 'View Results' en la notificación para abrir la imagen de resultado generada.

Revisa la imagen generada `_COLONY_PICK_output` y confirma la colonia resaltada junto con el resumen `number of colonies` que aparece en el resultado.